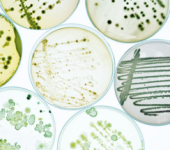
Cosméticos con antimicrobianos de plata FQC

En FQC nos gusta compartir artículos acerca de las tendencias, problemáticas y soluciones de las industrias en las que tenemos presencia para dar valor agregado a nuestros clientes.
¡Te invitamos a leerlos dando click o buscando el tema de tu interés!
Más resultados...
Pinturas autolimpiables con tecnología avanzada
Pinturas autolimpiables con tecnología avanzada Las pinturas autolimpiables con tecnología avanzada representan una evolución significativa en el sector de recubrimientos arquitectónicos e industriales. Su formulación combina el dióxido de titanio con silicato de magnesio hidratado, logrando una superficie más limpia, resistente y duradera. Esta sinergia permite mantener los acabados en óptimas condiciones durante más tiempo,…
Antimicrobianos seguros para cosméticos modernos
Antimicrobianos seguros para cosméticos modernos En la cosmética actual, la búsqueda de ingredientes seguros, sostenibles y eficaces ha impulsado una transformación profunda en las formulaciones. Los antimicrobianos seguros para cosméticos modernos marcan esta nueva etapa, reemplazando compuestos tradicionales como el triclosán por alternativas más responsables con la salud y el medio ambiente. Durante años, el…
Compatibilizantes que impulsan el reciclaje eficiente
Compatibilizantes que impulsan el reciclaje eficiente El reciclaje de plásticos es esencial para alcanzar una economía circular que reduzca el consumo de recursos y las emisiones de carbono. Sin embargo, uno de los principales desafíos es la mezcla de materiales incompatibles, que afecta la calidad del producto reciclado. En este contexto, los compatibilizantes que impulsan…
Protección de TPU con retardantes
Protección de TPU con retardantes El TPU (poliuretano termoplástico) es conocido por su flexibilidad, durabilidad y resistencia a la abrasión. Gracias a estas propiedades, se usa ampliamente en varias industrias. Se encuentra en sectores como la construcción, la electrónica, la automoción y la fabricación de calzado. Sin embargo, el TPU presenta un desafío: su alta…
Prebióticos para un equilibrio íntimo
Prebióticos para un equilibrio íntimo La salud íntima femenina depende en gran medida del equilibrio de su microbiota, una comunidad de microorganismos beneficiosos que actúa como barrera protectora frente a agentes patógenos. En los últimos años, el uso de prebióticos en productos de higiene íntima se ha consolidado como una estrategia eficaz para reforzar ese…
Innovación antimicrobiana con plata y óxidos metálicos
Innovación antimicrobiana con plata y óxidos metálicos En un entorno industrial donde la higiene, la durabilidad y la seguridad de las superficies son cada vez más importantes, la innovación antimicrobiana con plata y óxidos metálicos representa una solución de alto desempeño. Estos recubrimientos avanzados combinan la acción biocida de los compuestos de plata con la…
Seguridad sostenible con retardantes sin halógenos
Seguridad sostenible con retardantes sin halógenos La industria química ha avanzado de manera notable en el desarrollo de materiales más seguros y responsables con el medio ambiente. En este contexto, los retardantes de flama sin halógenos representan una solución moderna que combina desempeño, sostenibilidad y protección. Estos compuestos reducen la inflamabilidad de los materiales y…
Curativos en poliuretano
Curativos en poliuretano Los curativos en poliuretano son compuestos químicos que permiten transformar un prepolímero líquido en un material sólido, elástico y duradero. Su función es promover el entrecruzamiento molecular mediante una reacción con los grupos isocianato, creando una red tridimensional estable que define las propiedades mecánicas finales del poliuretano. La elección del agente de…
Máxima protección con poliuretano termoplástico
Máxima protección con poliuretano termoplástico En la industria del calzado de seguridad, cada detalle importa. Los trabajadores que enfrentan jornadas largas en ambientes industriales, mecánicos o de construcción necesitan un calzado que garantice protección, comodidad y resistencia. Dentro de los materiales que han revolucionado este sector, el poliuretano termoplástico (TPU) destaca por su capacidad de…
TPU en cables: flexibilidad y resistencia
TPU en cables: flexibilidad y resistencia El desarrollo de nuevos materiales ha transformado la manera en que se diseñan y fabrican cables eléctricos. Uno de los avances más relevantes de los últimos años es el uso del poliuretano termoplástico (TPU). Este polímero ha demostrado un excelente desempeño frente a materiales tradicionales como el PVC o…
Innovación verde: el nuevo plástico mexicano
Innovación verde: el nuevo plástico mexicano La crisis ambiental provocada por los residuos plásticos sigue siendo uno de los mayores desafíos de nuestro tiempo. Ante esta situación, México sorprende con una alternativa innovadora y prometedora: plásticos biodegradables elaborados a partir de la baba del nopal. Este desarrollo ha sido noticia a nivel internacional, no solo…
Cuidado facial para un lifting natural
Cuidado facial para un lifting natural El mercado cosmético global experimenta una creciente demanda de productos que ofrezcan beneficios visibles y multifuncionales. Dentro de estas tendencias, el cuidado facial para un lifting natural ocupa un lugar destacado, ya que los consumidores buscan alternativas eficaces que retrasen los signos de la edad sin recurrir a procedimientos…
Poliuretano en agua: rendimiento y protección
Poliuretano en agua: rendimiento y protección Los recubrimientos, adhesivos y tintas forman parte esencial de la vida cotidiana, desde los pisos y muebles hasta los vehículos que usamos a diario. Para garantizar su durabilidad y estética, las formulaciones actuales requieren materiales capaces de ofrecer resistencia, flexibilidad y un perfil ambiental responsable. En este contexto, el…
Tendencias de maquillaje en otoño 2025
Tendencias de maquillaje en otoño 2025 El otoño llega con nuevas formas de expresarnos a través del maquillaje. Este 2025 veremos rostros luminosos, labios intensos y miradas llenas de color. Sin embargo, más allá de las tonalidades que marcan moda, lo que realmente hace posible cada look son los ingredientes que dan vida a las…
TPU en la manufactura moderna
TPU en la manufactura moderna El termoplástico poliuretano (TPU) se ha consolidado como uno de los materiales más versátiles dentro de la industria contemporánea. Su combinación única de resistencia, flexibilidad y procesabilidad lo convierte en un aliado estratégico en sectores tan diversos como automotriz, eléctrico, textil, deportivo y de recubrimientos. En este artículo exploraremos qué…